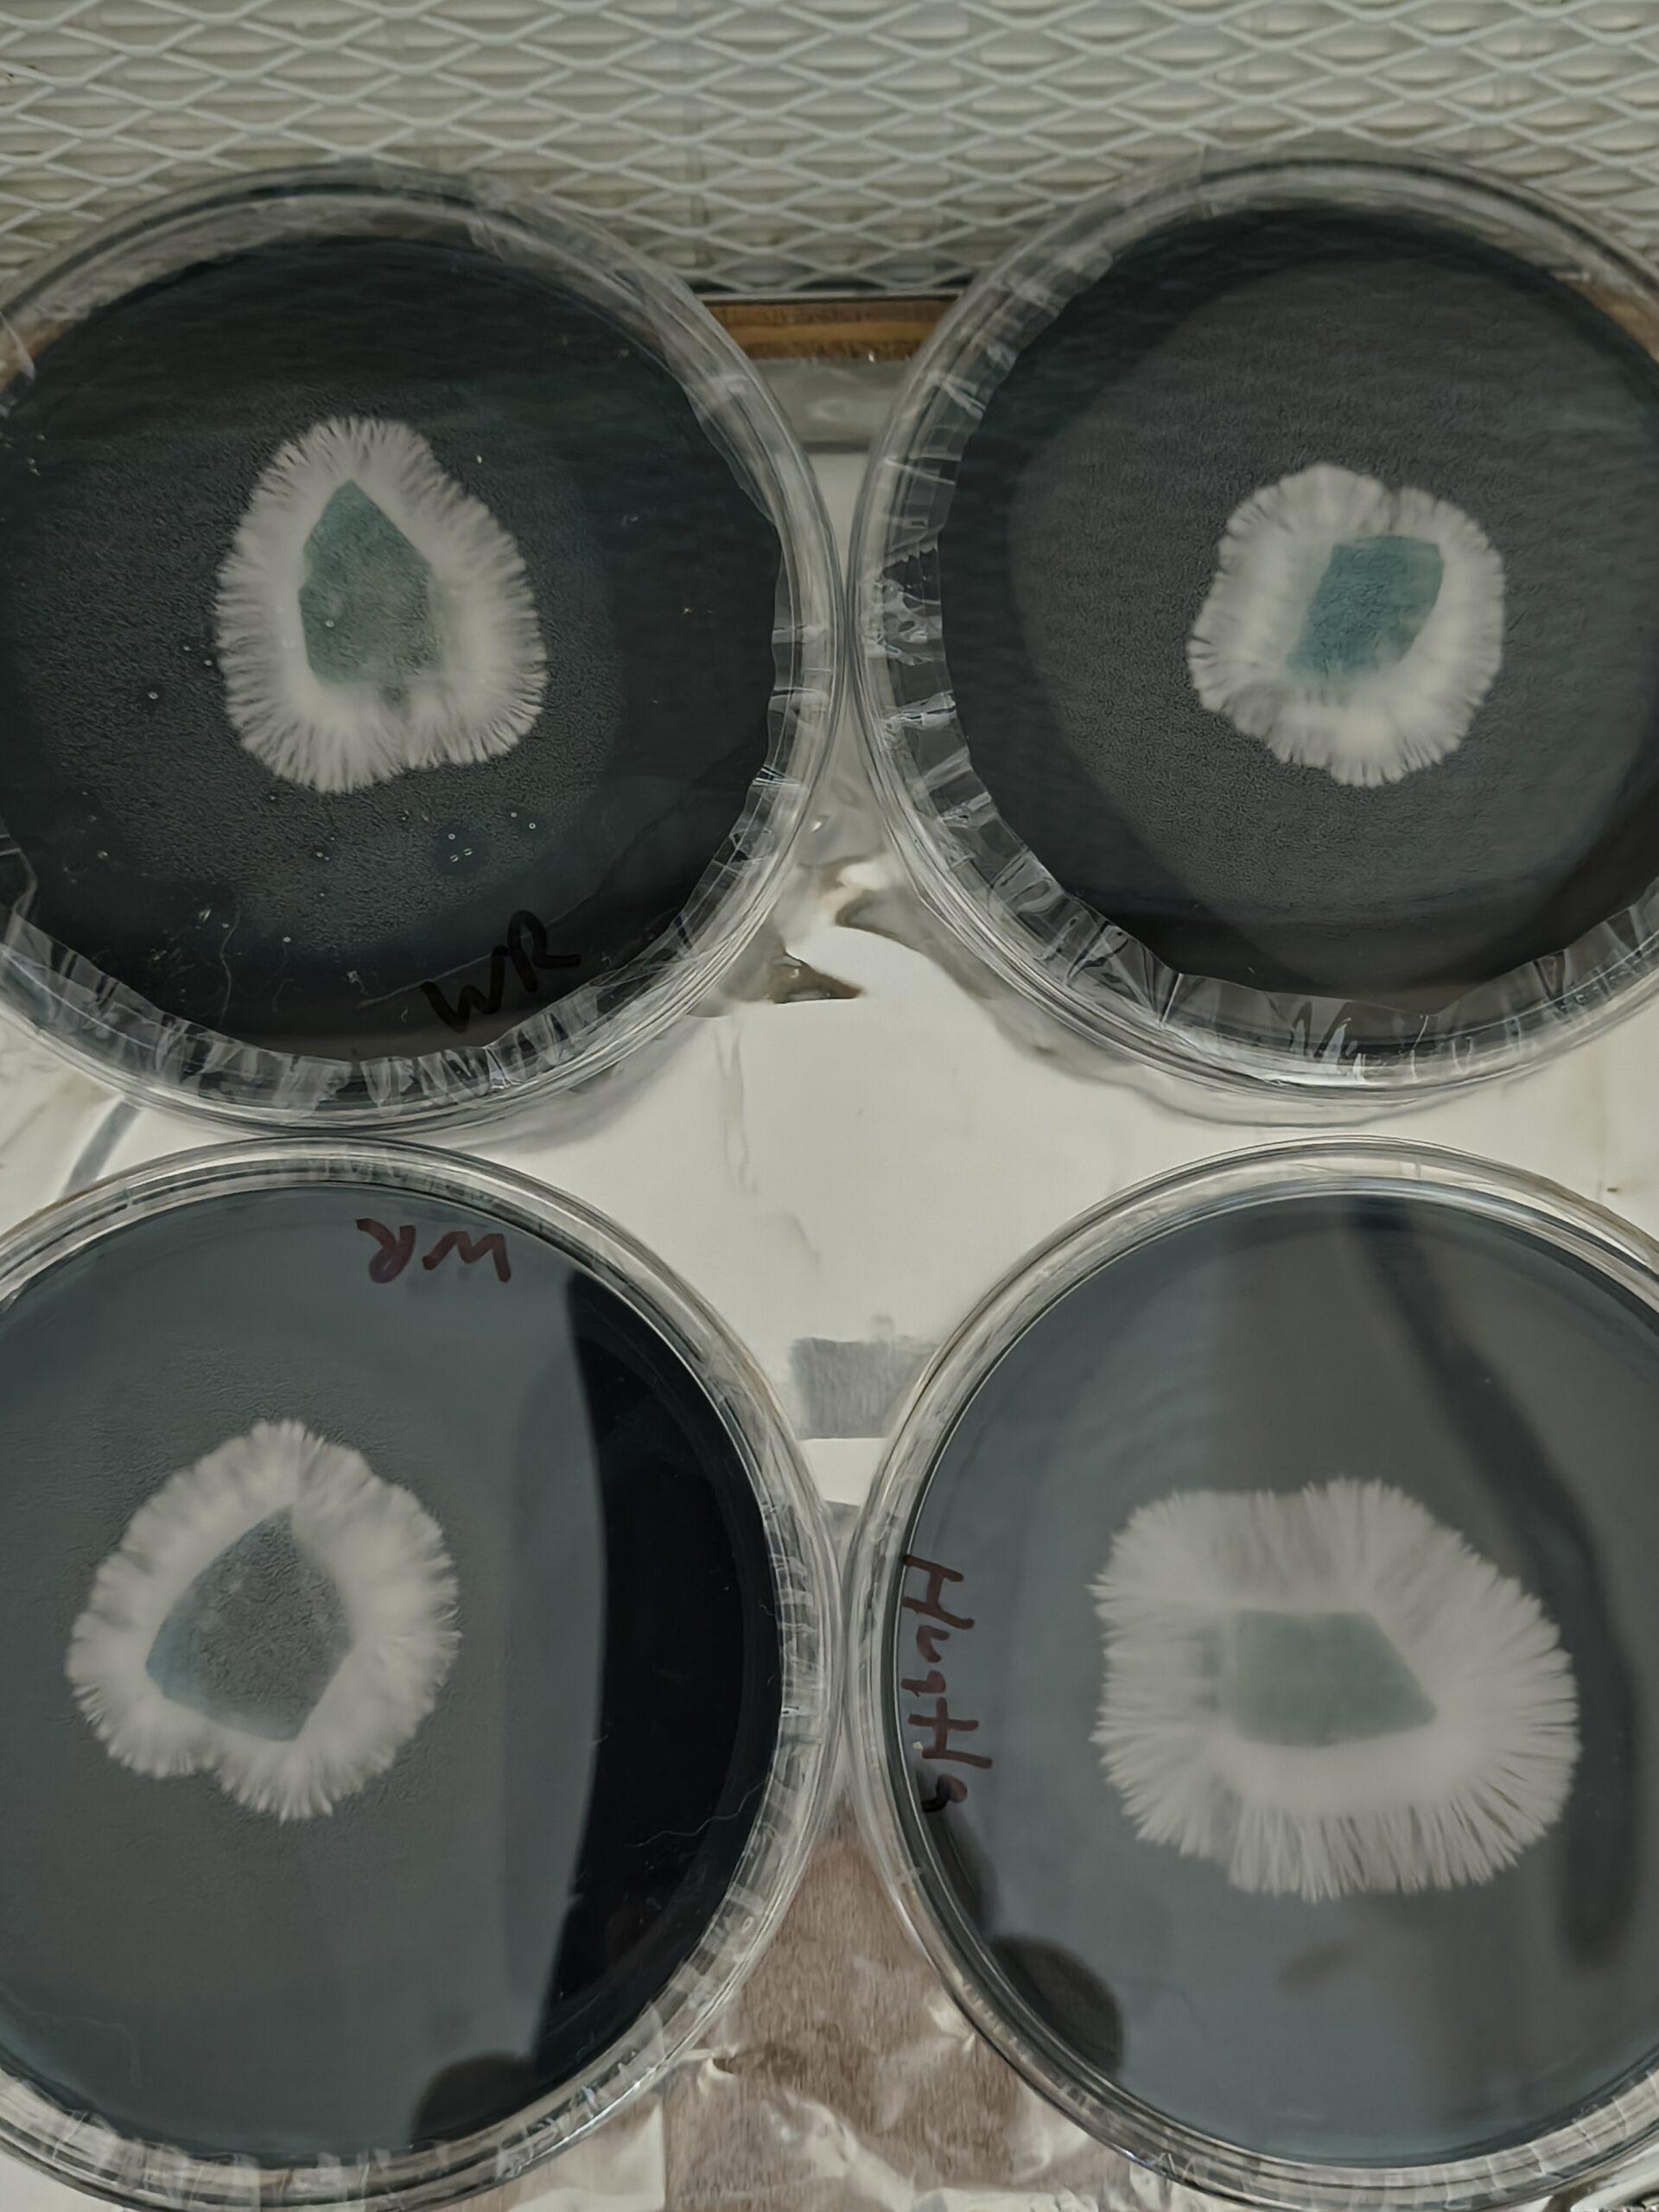

Only logged in customers who have purchased this product may leave a review.

Marvelous Mikes Fungal Forge
Ecuador Research Plate
$15.00
Ecuador The Andean High-Altitude Workhorse
The Forge is heading to the mountains! Originally discovered at over 1,000 feet above sea level in the Ecuadorian Andes, the Ecuador isolate is world-renowned for its rugged constitution and unwavering stability. This is a “truck-strong” strain—built to handle environmental fluctuations and keep pushing forward with relentless vigor.
For the researcher who values a specimen that is both classic and incredibly resilient, the Ecuador is a cornerstone of any professional microscopy library.
Genetic Characteristics & Research Notes
Mountain-Tough Resilience: Evolution at high altitudes has gifted this strain with a robust “immune system.”
Under the lens, it displays aggressive mycelial growth that is famously forgiving of minor environmental stressors, making it a premier study in adaptive genetics.
Aggressive Rhizomorphic Speed: This isolate doesn’t just grow; it colonizes with intent. On agar, it produces thick, beautiful, ropey strands that bridge sectors with high-velocity efficiency.
Iconic Morphology: The Ecuador is known for its classic, elegant appearance—spade-shaped, caramel caps and thick, sturdy, white stems. It is a highly consistent performer, offering a stable and predictable phenotypic expression that is a joy to document.
Laboratory Standard: Prepared in our sterile ISO-7 cleanroom in the heart of Ohio.
Forge-Certified: Like every specimen at the Forge, this Ecuador isolate has been vetted for its raw genetic power and cleanliness.
The Forge Standard
At Marvelous Mike’s Fungal Forge, we provide the steel for your scientific journey. We don’t settle for “good enough”—we hunt for the titans. Every culture is forged with precision, ensuring you receive the highest quality research material on the market.
Secure the Mountain Legend: Grab the Ecuador isolate and check out our full vault of heavy-hitters at our shop:
https://sporeswaps.com/vendors/marvelous-mikes-fungal-forge/
All Psilocybe cubensis spores are intended for microscopy and legal research purposes ONLY
Units Sold: 0
Shipping costs
| Shipping from | United States (US) |
| Within United States (US) | $8.00 |
National Shipping Details
| Minimum shipping charge per order | $8.00 |
| Maximum shipping charge per order | $8.00 |

Reviews
There are no reviews yet.